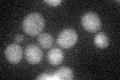
YJL157C
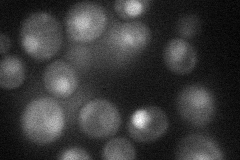
YJL157C
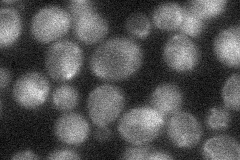
YJL157C
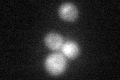
YJL157C

View description
Cyclin-dependent kinase inhibitor that mediates cell cycle arrest in response to pheromone; also forms a complex with Cdc24p, Ste4p, and Ste18p that may specify the direction of polarized growth during mating; potential Cdc28p substrate
Localization:
Intensity:
Fold change:
Significance:
-
C’ GFP library in SD
nucleus22.58 -
N' NOP1pr-GFP in SD
nucleus32.0834 -
N' TEF2pr-mCherry in SD

nucleus9.41997 -
N' NATIVEpr-GFP in SD
punctate,nucleus24.5302 -
N' TEF2pr-VC and Cyto-VN in SD

below threshold24.8599 -
C’ GFP library in SD+DTT
nucleusN/AN/ANo -
C’ GFP library in SD+H2O2

nucleusN/AN/ANo -
C’ GFP library in Starvation Media

nucleusN/AN/AYes -
C’ GFP library on the background of Pup2-DaMP

nucleus -
C’ GFP library on the background of CCT mutant

nucleusN/AN/ANo
